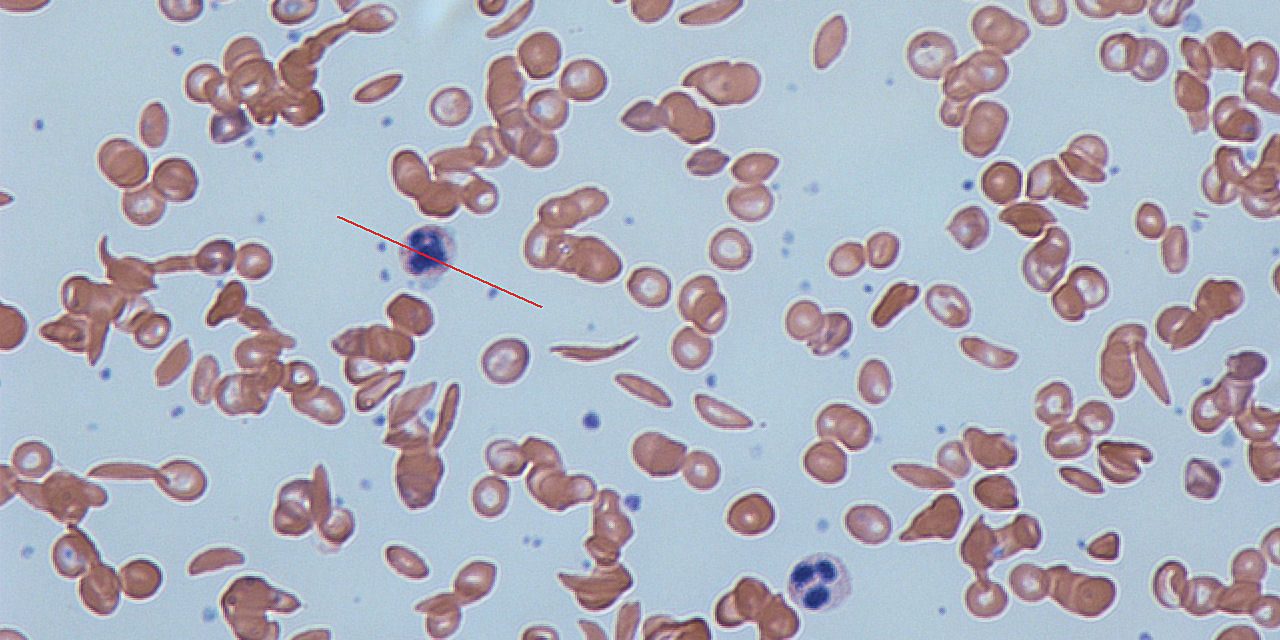
Sickle_cells

کمخونی داسیشکل به دلیل یک جهش نقطهای در ژن هموگلوبین بتا (HBB) رخ میدهد که بر روی کروموزوم 11 قرار دارد. این جهش باعث جایگزینی اسید آمینه گلوتامیک اسید با والین در موقعیت ششم زنجیره بتا هموگلوبین میشود. این جهش نقطهای در کدون ششم ژن HBB رخ میدهد و به عنوان p.Glu6Val یا rs334 شناخته میشود. البته در تست های آزمایشگاهی گاها برای ارزیابی این بیماری سکانس کامل ژن HBB مورد ارزیابی قرار میگیرد.
جزئیات جهش ژنی
این جهش باعث تولید هموگلوبین غیرطبیعی به نام هموگلوبین S (HbS) میشود. در شرایط کمبود اکسیژن، مولکولهای HbS تمایل به چسبیدن به یکدیگر دارند و تشکیل فیبرهایی میدهند که باعث تغییر شکل گلبولهای قرمز به شکل داسی میشود. این گلبولهای داسیشکل در رگهای خونی گیر میکنند، جریان خون را محدود میکنند و باعث ایجاد درد و آسیب به بافتها میشوند.
پولی مورفیسم و SNPهای مرتبط
پولی مورفیسم ژن HBB در موقعیت rs334 به عنوان یکی از شناختهشدهترین Single Nucleotide Polymorphisms (SNPs) در انسان است و مسئول ایجاد کمخونی داسیشکل میباشد.
علاوه بر rs334، سایر SNPها و ژنهای مؤثر بر شدت و تظاهرات بالینی کمخونی داسیشکل شناسایی شدهاند. برخی از این SNPها به تنظیم تولید هموگلوبین جنینی (HbF) و یا تغییر در پاسخهای التهابی بدن کمک میکنند. تولید بیشتر هموگلوبین جنینی (HbF) میتواند علائم بیماری را تخفیف دهد، زیرا HbF با HbS تعامل نمیکند و مانع از تشکیل فیبرهای داسیشکل میشود.
سایر ژنها و SNPهای مرتبط:
- rs7482144 (XmnI polymorphism): این SNP در ناحیه پروموتر ژن HBG2 قرار دارد و با افزایش تولید هموگلوبین جنینی (HbF) مرتبط است که میتواند شدت بیماری را کاهش دهد.
- BCL11A و HBS1L-MYB: پلیمورفیسمهای موجود در این ژنها نیز با تنظیم سطح HbF و شدت علائم مرتبط هستند.
- TLR4 و TNFα: این ژنها با پاسخهای التهابی مرتبط هستند و پلیمورفیسمهای موجود در آنها میتواند شدت التهاب و بحرانهای داسیشکل را تحت تأثیر قرار دهد.
این پولیمورفیسمها به عنوان نشانگرهای ژنتیکی برای پیشبینی شدت بیماری و پاسخ به درمانها مورد مطالعه قرار گرفتهاند. مطالعات ژنتیکی بیشتر بر روی جمعیتهای مختلف میتواند به درک بهتر نقش این پولیمورفیسمها و توسعه روشهای درمانی هدفمند کمک کند.